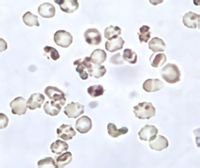
尿常規上皮細胞

臨床意義
尿常規上皮細胞
尿常規上皮細胞扁平上皮細胞,一般臨床意義不大。移行上皮細胞因來源不同,有表層、中層、底層移行上皮細胞之分,其中中層移行上皮細胞增多常見於腎盂腎炎等。小圓形上皮細胞來自腎,正常尿中少見,腎小管病變時可大量出現,對腎實質疾病的定位診斷有一定價值。當腎慢性充血、腎梗塞及血紅蛋白沉著時,可見胞質內含有棕色顆粒(含鐵血黃素)的圓形細胞。
上皮細胞
正常人的尿液中,有時可發現少數上皮細胞。如果有腎小球腎炎時,尿中上皮細胞會增多,如果腎小管有病變時,可出現許多上皮細胞,有時陰道分泌物混入尿液中也會有許多。
如果只是在尿常規檢查時上皮細胞數值較高,而尿蛋白,紅細胞數值正常,應該不會出現大的問題,要注意定期檢查。

